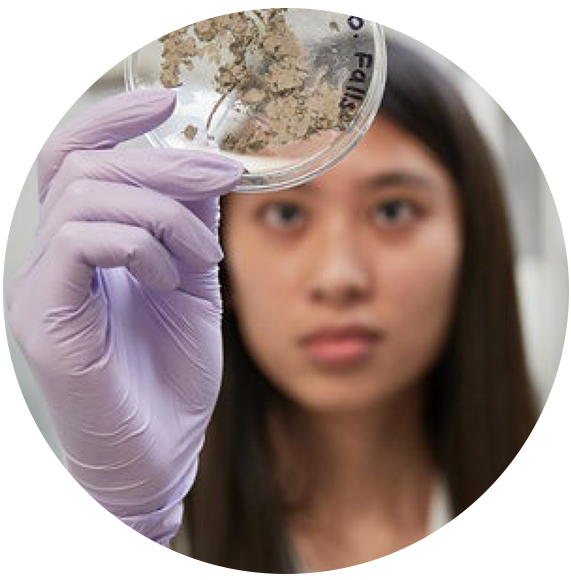

CIHR Institute of Infection and Immunity (III) – Strategic Plan 2021–2026
Table of Contents
- Message from the Scientific Director
- Strategy at a Glance
- The Institute & the Power of Science in the 21st Century
- Our Strategy
- Strategic Goals
- Cross-Cutting Principles
- Performance Monitoring and Learning
- Impact
- Acknowledgements
Message from the Scientific Director

Dear Colleagues,
A lot has changed since we started the planning process in Fall of 2019 for the CIHR Institute of Infection and Immunity (III)’s Strategic Plan 2021-2026. In the short span of 18 months, we have experienced first-hand how a new, untreatable infectious disease can have a vast impact on every aspect of our lives. The COVID-19 pandemic magnified the substantial health inequities that exist around the world, including here in Canada. The continued egregious instances of discrimination against Indigenous communities and communities marginalized by race, including Black communities and other people of color, have further amplified the urgency to eliminate racism in research and the research environment and address the underlying social determinants of health that perpetuate health disparities. Now more than ever, all eyes are focused on research to aid in the betterment of society, and we must leverage the power of science to help address these global health issues.
Thanks to the resilience of our researchers and the excellent stewardship of my predecessors, Drs. Bhagirath Singh and Marc Ouellette, infection and immunity research in Canada has grown into a thriving, well-established community over the last 20 years. Now, we need to build on our successes and foster a more connected, inclusive, and diverse scientific community, well-equipped to solve the complex global issues and the emerging health challenges of the 21st century. Only through innovative and transdisciplinary approaches can we tackle future pandemics, climate change and growing prevalence of chronic diseases and antimicrobial resistance.
I am excited to announce our Strategic Plan 2021-2026. This plan is bold and forward looking—it demonstrates commitment to build and enable leadership capacity in Canada, focuses on strategic areas that need attention now, and provides flexibility to pivot to emerging issues that may require surge capacity. It achieves impact by enabling diverse and inter- and transdisciplinary team science to lead the way. It also supports the intentions of the CIHR Strategic Plan 2021-2031, which provides an overarching strategy for CIHR to demonstrably improve the health of people in Canada and throughout the world.
I would like to express my sincere thanks to the close to 750 Canadian stakeholders and international partners who shared their ideas, knowledge, and time with us during our consultation process. I sincerely hope you will see yourself reflected in this plan. A special thanks to my Institute team for their singular dedication, and other CIHR Institutes, especially the Institute of Indigenous Peoples’ Health (IIPH), and our CIHR colleagues in Ottawa for their steady support throughout this process. Our Institute Advisory Board has tirelessly guided us through our engagement with our communities, and provided valuable feedback to improve our plan at each milestone of the development process. Finally, I would like to thank the research community and CIHR management for entrusting me with this important role. I feel privileged and honored to lead this Institute into its next phase, and I am optimistic that by working together, we will drive excellent infection and immunity research for equitable health outcomes in Canada and around the world.
Charu Kaushic, PhD
Scientific Director, Institute of Infection and Immunity
Strategy at a Glance
The Institute of Infection and Immunity (III), one of the 13 virtual CIHR institutes, has the mandate to support research and build capacity in the areas of infectious disease and the immune system. Our mandate transcends disciplines and encompasses all four CIHR health research pillars: biomedical, clinical, health systems services and population health.
The III Strategic Plan 2021-2026 focuses on a shared responsibility between III and our research community to work together on 21st century problems. Through our position within CIHR and our connections with other CIHR institutes, we amplify opportunities for our research community. We are dedicated to creating a research environment that propels Canada to the forefront as a global leader in infection and immunity research while also supporting the delivery of CIHR’s mandate and strategic priorities. We envision an Institute that is home to a diverse community of highly- connected researchers that collaboratively drive research impact through strong partnerships with people with living and lived experience, health practitioners, the public, industry, decision makers, and international allies. Together, we will strive to leverage the power of science to achieve equitable health outcomes for all in the 21st century.
Our Strategic Framework

Long description
Values:
- Act with integrity, transparency, and accountability in making decisions, setting priorities and assessing the outcomes and impact of our strategic investments.
- Be flexible and proactive to ensure our work remains relevant within a rapidly evolving research environment.
- a rights-based, anti-racist, gender equitable research environment
- Achieve organizational excellence by staying true to our values and cross-cutting principles and not compromising on the quality of work and leadership needed for the Institute to support the infection and immunity research community.
- Foster a learning system that enables evidence-based decisions and continuous improvement of initiative design and implementation, administration of funds and communication of results.
Strategic Goals:
- Global Threats
- 21st Century Infection & Immunity Priorities in Canada
- Building Careers
- Infection & Immunity Knowledge Mobilization
The following cross-cutting principles will be applied to drive the Strategic Goals
- Equity, Diversity & Inclusion (EDI)
- Communications & Engagement
- Monitoring and Learning
- Collaboration & Partnerships
The Institute & the Power of Science in the 21st Century
Infection & Immunity Research Matters
If ever there was a time when infection and immunity research was at the forefront of everyone’s mind, the years of the COVID-19 pandemic were it! The rapid spread of SARS-CoV-2 resulted in a major upheaval to lives, health systems, and economies around the world. Science has been the lifeline that allowed us to develop and apply the medical and social countermeasures needed to exit from this global health emergency. It is also the pillar on which we can lean on to address emerging challenges like variants, collateral impact of COVID-19, recovery from the current pandemic and preparation for future global pandemics.
Even before COVID-19 struck in 2020, 6 out of 13 of the WHO’s listFootnote 1 of most urgent threats to global health over the next decade were either driven by infectious disease or were linked to infection and immunity-related challenges. These included epidemics, the spread of infectious disease, antimicrobial resistance (AMR), the climate crisis, health inequity, and water sanitation and hygiene in healthcare settings. Even as major progress has been made by prevention efforts, timely diagnosis and safe, effective and affordable treatments in reducing the incidence, morbidity and mortality from HIV, TB, and viral hepatitis, the work is far from over. We need to accelerate our efforts if we are to meet the international targets, including the 2030 UN Sustainable Development Goals, the UNAIDS 90–90–90 - An ambitious treatment target to help end the AIDS epidemic and the WHO End TB Strategy, all endorsed by Canada. Other global threats such as vector-borne infections driven by climate change and AMR continue to grow and cannot be solved by any one nation. Only through global solidarity and creativity will we avert these looming crises.
While controlling infectious diseases remains an urgent priority, death rates from chronic diseases are rising and before COVID-19, contributed to over 50% of deaths worldwideFootnote 2. Canada’s top two causes of death, cancer and heart diseaseFootnote 3, are both driven and exacerbated by inflammation and dysregulated immunity. Immunity research has been a cornerstone in advancing treatments for chronic diseases in the past decade, as we learned to manipulate immune responses for novel and effective interventions. However, a persistent sedentary lifestyle, environmental pollutants, unhealthy diet, and aging will continue to feed into the chronic disease epidemic. Solving these challenging issues will depend on our capacity to understand and address the intersections between social, environmental and biological factors.
Looking ahead, III and the Canadian infection and immunity research community are well positioned within a rapidly changing research environment to continue leading – nationally and globally – the development of innovative solutions for the infection and immunity challenges of the 21st century. We believe the current Strategic Plan will enable us, together with our research community, to be proactive and strategic in tackling these infection and immunity challenges with confidence.
About The Institute
The Institute
III is one of the 13 Institutes of the Canadian Institutes of Health Research, Canada’s health research investment agency. Our mandate is to support research, build capacity and mobilize knowledge in the areas of infectious disease and the immune system. This mandate transcends disciplines and encompasses all four CIHR health research pillars.
Since 2001, we have led and collaborated on strategic opportunities to address the needs and priorities within the Canadian infection and immunity research environment and catalyze and synergize the excellent research supported by CIHR’s investigator-initiated program. Currently, we support researchers through 28 ongoing strategic initiatives, including major strategic initiatives like vaccines, human immunology, and microbiome. We also provide scientific and strategic leadership for 6 Government of Canada Priorities relevant to III’s mandate, including the Sexually Transmitted and Blood-Borne Infection (STBBI) Research Initiative (formerly the HIV/AIDS Research Initiative), AMR Initiative, Canadian Immunization Research Network and the Hepatitis C Initiative. In 2020-21 III also contributed significantly to CIHR’s COVID-19 research response.
As part of CIHR, we work closely with other government departments and agencies so that emerging evidence for major public health issues is brought to decision makers. In her function as Scientific Director of III, Dr. Kaushic participates in multiple national leadership tables and has advised decision-makers during the COVID-19 pandemic. This includes roles as Coordinator of the Immune Science Group and Executive Committee member of the COVID-19 Canadian Immunity Task Force (CITF), as well as member of the National Variants Leadership Group. Our Institute also contributed to the development of Canadian strategies to guide multi-sectoral and concerted actions to address major health concerns, including the Pan-Canadian AMR Framework, the forthcoming Pan-Canadian AMR Action Plan, and the Pan-Canadian STBBI Framework for Action and its five-year Action Plan.
III has also contributed to Canada’s leadership on the global stage. To this end, Dr. Kaushic, as CIHR’s representative, was elected as the Chair of the Global Research Collaboration for Infectious Disease Preparedness (GloPID-R), and a member of the Steering Committee of the Joint Programming Initiative on AMR (JPIAMR). GloPID-R is a global consortium of funders that aims to enable a coordinated, rapid and effective research response to infectious disease threats and JPIAMR is a global collaborative aiming to curb AMR with a One Health approach.
Through our programs and leadership roles, we also elevate the profiles of Canadian researchers by connecting them with the global research community through participation in funding programs and international organizations, thereby creating opportunities for international leadership and global knowledge exchange.
Overall, we work to leverage funding, form partnerships, share resources, mobilize knowledge, communicate with our community and the public, and amplify the impact of research in Canada and abroad.
III's Strength in Numbers
2,913 infection and immunity stakeholders & partners connected to III
Catalyzing Research & Fostering Partnerships
- Annually, Infection & Immunity research leverages $38.6M in partnership
- 191 research projects supported through 63 funding opportunities since 2015
- 84 national and international Funding Partners since 2015
Scientific Leadership on Government of Canada Priorities
- Scientific leadership on initiatives from 6 Government of Canada Priorities representing an annual budget of $30.1M
- Led or helped shaped an investment of $208M in COVID-19 investment through 10 initiatives between January 2020 to March 2021
Mobilizing Canada's Science
- 57 media interviews since 2018Footnote *
- 12 news articles, opinion pieces and scientific publications since 2018Footnote *
- 45 talks where III represented its Scientific community since 2018Footnote *
- 32 national & international events where III enabled the participation of Canadian scientists since 2018Footnote *
Building Canada's Research Capacity
- 17 Bhagirath Singh Early Career Awards granted for outstanding research since its creation in 2010
- 144 individuals supported directly through training & career awards and workshops since 2015
Maximizing the Impact of Our Strategic Investments
III has a strong track record of leveraging its annual strategic budget of $8.6M to significantly increase the impact of our investments across our strategic priorities and across all four research pillars.
The Canadian Microbiome Initiative (CMI), the Canadian Donation and Transplantation Research Program (CDTRP), and the Health Challenges in Chronic Inflammation initiative (HCCI) demonstrate the value of III strategic investment. These initiatives built on the previous successes of the Institute and in partnership with other CIHR Institutes, established strong and connected research communities across Canada, and fostered synergies through interdisciplinary teams. CMI positioned the Canadian research community with the right infrastructure to successfully leverage competitive funding through CIHR's investigator-initiated program, amplify the impact of investments and place Canada among the world's leaders in microbiome research. The CDTRP initiative (Canadian National Transplant Research Program – CNTRP - at its inception) played a key role in bringing together transplant researchers, donors, patients and other stakeholders into a single network that has successfully leveraged $50M in partnerships and open funding.
The Catalyzing Power of Strategic Investment
Accelerating the Emerging Field of Microbiome Research in Canada 2007-2025
Timeline

Long description
- 2008 – III & partners host the Canadian Microbiome Workshop
- 2009 – III & 1 CIHR partner fund 12 Catalyst grants, $1.2M
- 2010 – III, 3 CIHR partners & 5 external partners fund 7 Emerging Team grants, $15.5M
- 2014 – III & partners host the second Canadian Microbiome Workshop
- 2018 – III & 7 CIHR partners fund 1 ongoing pan-Canadian Research Core, $3.4M
- 2019 – III, 7 CIHR partners & 2 external partner fund 7 ongoing Research Teams, $14.2M
Impact on the research environment from $34.3M in strategic investment
- Catalyzed $120M total CIHR investment in microbiome
- 136 researchers and highly qualified personnel in microbiome researchFootnote **
- 526 scientific publications and products originated from the Catalyst and Emerging Team grantsFootnote **
- An additional $30.9M leveraged from the Emerging Team grants through external funding and partnershipsFootnote **
"The microbiome catalyst grant was truly the catalyst for my research in this field. It has now resulted in close to $20M in additional funds, more than 70 publications, over 10 fruitful collaborations, a clinical trial and spin-off biotech company."
"The microbiome emerging team grant produced 40+ papers and trained just as many students. Three of my postdoctoral fellows obtained assistant professor or senior analyst positions, and one now co-leads a CIHR microbiome research team grant."
Defining New Directions for 21st Century Infection & Immunity Science
Intent on understanding emerging priorities while building on the successes of the Strategic Plans 2013-2020, III began a highly consultative process in 2019 to prioritize III’s strategic efforts for the next 5 years. The new plan was shaped by a broad engagement process that gathered feedback from close to 750 infection and immunity stakeholders from across Canada, in addition to international partners. Researchers, trainees, partners, practitioners, policy makers, advisory board members, patient groups and Indigenous health researchers and health organizations shared their insights and recommendations via a variety of qualitative and quantitative consultation methods. The most frequently identified priorities emerging from our broadly disseminated survey informed the discussion of 8 Canada-wide workshops. The priorities that emerged from these workshops were further refined through 9 focus group discussions. The final framework was validated with our Institute Advisory Board through a consensus-based approach.Footnote *** The Strategic Plan 2021-2026 reflects what we heard during this inclusive and diverse consultative process and sets out priorities that align with the CIHR Strategic Plan 2021-2031 and the STBBI Research Initiative Strategic Plan (under development).
Our Strategy
Vision
Excellence in infection and immunity research that leads to equitable health outcomes for people in Canada and around the world in the 21st century.
Mission
To establish, engage and mobilize an inclusive, collaborative and diverse research community focused on excellent research that addresses infection and immunity priorities in Canada and beyond.
RESEARCH EXCELLENCE
The CIHR Strategic Plan 2021-2031 champions a more inclusive concept of research excellence. III will work with CIHR as a whole to develop, implement, and champion a more inclusive concept of research excellence. We recognize that research excellence is more than a journal impact factor. It is multidimensional and includes the quality of contributions in advancing the field, publication record, reproducibility of research, multiple ways of knowing, open science, collaborations, community-based research, influence on policy, engagement activities, mentorship and science communication. As such, we will reinforce CIHR’s policy directions consistent with the signing of the San Francisco Declaration of Research Assessment (DORA), CIHR’s Sex and Gender-based Analysis Action Plan, Tri-Council Statements on Equity, Diversity and Inclusion and Open Access Policy on Publications.
Excellent research has maximal impact. This can be achieved when people with living and lived experience, healthcare providers, policy makers, industry, the public and other users of research outputs are active collaborators throughout the entire research process.
Values
Our values guide us. They shape our culture, and influence our decisions and actions on a daily basis as we work to achieve our strategic goals. As a CIHR Institute, III is committed to upholding the values and commitments of the organization which are excellence and leadership, commitment to collaboration, respect for people and integrity and accountability. This means that over the next 5 years III will:
- Act with integrity, transparency, and accountability in making decisions, setting priorities and assessing the outcomes and impact of our strategic investments.
- Be flexible and proactive to ensure our work remains relevant within a rapidly evolving research environment.
- Champion a rights-based research environment that is anti-racist, promotes gender equity and recognizes the effects of intersectionality.
- Achieve organizational excellence by staying true to our values and cross-cutting principles and not compromising on the quality of work and leadership needed for the Institute to support the infection and immunity research community.
- Foster a learning system that enables evidence-based decisions and continuous improvement of initiative design and implementation, administration of funds and communication of results.
Strategic Goals
Strategic Goal: Global Threats
Position Canada as a Leader in the Research Response to Global Infectious Disease Threats
Preparing for and responding to current and emerging infectious disease threats is an enduring priority of III – and its importance has since been heightened by COVID-19. Climate change, rising global interconnectivity and population density, continuing environmental degradation, persisting social inequities, and increasing resistance to antimicrobial treatments have created the perfect storm where infectious disease outbreaks and health emergencies will become more frequent and costly for our societies.
The opportunity to avoid future pandemics and catastrophic health emergencies will depend on our capacity to better prevent and prepare for timely responses. While pandemic prevention and preparedness will need billions of dollars, the cost of a pandemic is measured in trillions of dollars and millions of lives lost. Recognizing the importance of being proactive, III is committed to contributing to the national and international efforts to prevent and prepare for future global infectious disease threats. This goal can only be achieved through global coordination because as COVID-19 has shown, no one is safe until everyone is safe. Through its international leadership roles in GloPID-R and JPIAMR, III is enabling Canadian researchers to lend their expertise globally, ensuring Canada is contributing to the international research response to global health threats and benefiting from these efforts.
This Strategic Goal aligns with CIHR’s strategies to drive progress on global health research and enhance rapid response capacity to pandemics and health emergencies, since these infectious disease threats do not recognize any boundaries. We will continue to learn from our experience with COVID-19 and apply our successes and renewed understanding of a proactive, collaborative approach to other global health threats, like AMR and zoonotic diseases emerging and spreading due to climate change.
Strategic Priorities
- Prevent with a focus on vaccines, prepare for, and respond to global infectious disease threats.
- Identify, understand, and prevent zoonotic diseases emerging and spreading due to climate change.
- Advance the application of a One Health approach in research to reduce antimicrobial resistance.
A Path Forward
We will invest and build capacity in research focused on preventing climate change-driven zoonotic diseases and other global emerging infectious diseases. Through our scientific leadership and strategic investments, we aim to accelerate research on infectious diseases with epidemic potential and actively participate in the consolidation of the essential infrastructure, capacity, skills, and partnerships. Canada needs these to be in place to identify future threats and rapidly mobilize to generate the evidence, vaccines, diagnostics, treatments, and interventions needed in the event of future infectious disease outbreaks. The Pan-Canadian AMR Action Plan recognizes the interconnection between people, animals, and the environment. III will align with this plan to coordinate research within Canada and globally to advance One Health approaches to prevent zoonotic transmission and reduce the prevalence of AMR.
Examples of How We Will Evaluate Success
- 1-3 Years
- Increase in the number of infection and immunity research initiatives strengthening research on the identification, prevention, preparedness and response to global infectious disease threats.
- 5 Years
- Increase in the number of connections established between III, its researchers and international global health stakeholders.
- Growth in the number of investigators applying a One Health approach to advancing research on identification, prevention, and response to global infectious disease threats.
Anticipated Outcome
Canada is recognized as a world leader in research on prevention, preparedness and response to global infectious disease threats, and its world-class Canadian infection and immunity research community is a key international collaborator in developing the solutions needed to maximize global security against infectious disease threats.

Strategic Goal: 21st Century Infection & Immunity Priorities in Canada
Realize the Full Potential of Infection & Immunity Research to Improve the Future Health of All Canadians
A range of social and environmental factors influence equitable health outcomes in both chronic and infectious diseases. As the Scientific Lead on the Government of Canada STBBI Research Initiative, III has launched strategic funding opportunities to address the disproportionate impact of HIV/AIDS on gay, Black, Indigenous, and other key populations in Canada and around the world. Beyond HIV, we know that the incidence and health outcomes of cardiovascular disease, diabetes, or tuberculosis are highly influenced by social and structural factors. It is only by understanding these determinants and their intersections with other biological factors that research can provide the best health for all.
To realize the full potential of research to tackle these complex and intersecting infection and immunity challenges, researchers from diverse fields must come together to develop inter- and transdisciplinary approaches. Only through diversified teams will we spark the creative and innovative power needed to advance the development of and access to diagnostic, prevention, intervention, and care solutions that will improve the health of all Canadians in the 21st century.
Aligned with CIHR’s priority to pursue health equity through research, this III Strategic Goal speaks directly to the future infection and immunity research priorities most pertinent to Canada. Preventing and treating the inflammatory aspects of chronic disease is a priority for the Institute. We will proactively work with our community to address these health challenges in aging and other high-burden populations. We are also committed to focusing on building relationships with Indigenous communities and scholars to co-develop initiatives that address health disparities in First Nations, Inuit and Métis.
Strategic Priorities
- Support research on prevention and treatment of high-burden chronic and inflammatory diseases.
- Focus on First Nations, Inuit and Métis Peoples’ self-determined health priorities related to infection and immunity.
- Address the underlying biological, social and environmental determinants of health to enhance equitable outcomes of infection and immunity diseases in disproportionately affected populations.
- Support discovery research to understand and address the infection and immunity issues that will shape Canada’s future health priorities.
A Path Forward
We will advance strategic initiatives that span discovery through to applied research and build capacity in areas that focus on alleviating high-burden chronic and inflammatory diseases; developing a better understanding of the underlying infection and immunity-related causes of chronic disease; and identifying tailored approaches to reduce the burden of current and emerging infection and immunity diseases that most heavily impact Canadians or manifest significant health inequities.
Examples of How We Will Evaluate Success
- 1-3 Years
- Increase in the number of infection and immunity team-based research initiatives focused on preventing and treating chronic and inflammatory diseases and improving health equity in disproportionately affected populations.
- 5 Years
- Increase in research activity engaging diverse teams, fostering integration across discovery, clinical, health services and population health research and contributing to equitable health outcomes for Canada's infection and immunity priorities in the 21st century.
Anticipated Outcome
A diverse Canadian infection and immunity research environment that conducts excellent, inter- and transdisciplinary research on Canada's future infection and immunity priorities, fosters integration across discovery, clinical, health services and population health research, and contributes to equitable health outcomes for all Canadians.
Collaboration Among Disciplines to Solve a Common Problem
In multidisciplinary research, investigators work in parallel or sequentially from a disciplinary-specific base. In interdisciplinary research, investigators work together throughout the research process, but still from a disciplinary-specific base. In transdisciplinary research, investigators work together using a shared conceptual framework that integrates disciplinary-specific theories, concepts, and methods. With a transdisciplinary approach, diverse stakeholders, such as people with living and lived experience, academics, and policy makers, cooperate through mutual learning to devise new solutions to complex research questions that span disciplines.

Grounding Infection and Immunity Research in First Nations, Inuit and Métis Health and Wellbeing Perspectives
A Word of Thanks
We would like to thank the First Nations, Inuit, and Métis researchers and Indigenous Health organizations who joined us in a meaningful dialogue, where we listened, learned, and reflected together on the development of our new Strategic Plan. We also thank IIPH Scientific Director, Dr. Carrie Bourassa, and her staff for their help in the engagement process and guidance in developing this section.
Our Commitment to Reconciliation
In alignment with the CIHR (2021-2031) and IIPH (2019-2024) Strategic Plans, III's Strategic Goal: 21st Century Infection and Immunity Priorities in Canada will include a focus on research driven by First Nations, Inuit and Métis communities, including Urban Indigenous people, and grounded in Indigenous and decolonizing methodologies. A commitment to reconciliation will guide our approach and actions and ensure our initiatives are truly collaborative and participative across all phases of research, and respect Indigenous cultures, values, beliefs and knowledge systems. Following the advice received during our Indigenous engagements, the following key principles will guide our activities:
III commits to continuing to build relationships with First Nations, Inuit and Métis communities with the understanding that building reciprocal, trusting relationships takes time.
Self-determination & Self-governance
Respecting the right of Indigenous Peoples to have sovereignty of their own research and data through a distinction-based approach, including setting their own research priorities, and ensuring Indigenous communities are engaged in the research process, with access to disaggregated data so it may be analyzed, interpreted and shared in ways that are meaningful to the communities.
Reciprocity & Equality
Promoting a reciprocal exchange and equal partnership between Indigenous Ways of Knowing and Western approaches to improve the physical, mental, emotional, and spiritual life of Indigenous and non-Indigenous communities involved in research.
A Path Forward
Over the next 5 years, III will commit to actions that are consistent with addressing health inequities rooted in the ongoing legacy of colonialism. During our strategic planning process, distinction-based research priorities vital to the holistic health and wellbeing of Indigenous communities were identified, such as addressing tuberculosis in Inuit communities, water security in remote communities and the roles of social inequity and climate change in infection and chronic inflammatory conditions. The need for building capacity and training programs led by Indigenous scholars was articulated. Using these as a starting point for further dialogue, we will co-develop with Indigenous communities and organizations new ways to generate the knowledge and build the capacity for Indigenous communities to improve the health and wellbeing of First Nations, Inuit and Métis Peoples in Canada. Through this process, we will contribute to CIHR's commitment to accelerating the self-determination of Indigenous Peoples in health research.
Examples of How We Will Evaluate Success
- 1-3 Years
- Increase in the number of relationships built and sustained with First Nations, Inuit and Métis and/or Urban Indigenous communities for III to listen and understand the self-determined health research priorities related to infection and immunity.
- 5 Years
- Growth in the number of meaningful partnerships led by and co-developed with Indigenous researchers and communities to address self-determined priorities for the health and wellbeing of First Nations, Inuit and Métis.
Anticipated Outcome
Reciprocal, trusting relationships between III, infection and immunity researchers, and First Nations, Inuit, and Métis communities that thrive within a research environment that recognizes distinctiveness and where Indigenous communities are leading Indigenous research and capacity building, progressing towards equitable health outcomes.

Strategic Goal: Building Careers
Enable the Current and Next Generation of Researchers to Collaborate and Lead in the Evolving Infection and Immunity Research Environment
The use of novel technologies with the power to foster innovation, open science, and team science will be key to driving the discovery and out-of-the-box thinking needed to tackle the infection and immunity-related health priorities of the 21st century and position Canada as a leader in the research response to global infectious disease threats. Breakthrough discovery and innovation are fueled by inter- and transdisciplinary research and diversity. To achieve the full potential of the Canadian infection and immunity research community, we therefore need a diverse community that is bold with their ideas, inclusive in their collaborations and scientific methods, and enabled by their research environment. We need to celebrate diversity and transform it into a core strength of Canada’s research.
Developing the next generation of infection and immunity leaders is a priority for III. We will focus on early career investigators and continued support and leadership opportunities for mid-career investigators. Developing expertise and training in next-generation technology will be key to their success.
This Strategic Goal aligns with CIHR’s commitment to fostering sustainable research careers and their priority to advance research excellence in all its diversity. III will champion a more inclusive concept of research excellence and focus on providing opportunities for underrepresented groups, recognizing the cumulative effects of the challenges faced by underrepresented groups over a researcher’s career. We will strive for all researchers to pursue fulfilling careers across their lifespan, within an equitable, diverse and inclusive research environment, and with the skills they need to lead the Infection and Immunity research of the 21st century.
Strategic Priorities
- Support researchers across academic lifespan with a focus on enabling smooth career transitions and addressing barriers experienced by early- and mid-career researchers and underrepresented groups in growing their research careers.
- Develop training initiatives to equip researchers with the expertise and skillsets needed to integrate new technologies and methods into their research.
- Build relationships and platforms for collaboration to enable team science, and inter- and transdisciplinary approaches.
A Path Forward
We will continue to invest in career growth opportunities for infection and immunity researchers, ensuring that top talent—especially early career investigators who often bring innovative yet higher risk ideas to researchFootnote 4—is attracted to and retained within Canada. We will also focus on supporting mid-career investigators, a priority identified in the 2018 Institute External Review. We will strengthen Canada’s creative and innovative potential by supporting researchers from underrepresented groups through targeted funding and networking opportunities. Moreover, recognizing how women and parents of young children in our research community have experienced disproportionate disruptions due to the COVID-19 pandemic, we will aim to help reduce the impact of these disruptions on their research programs by building flexibility in our operational requirements.
Examples of How We Will Evaluate Success
- 1-3 Years
- Increase in the number of III mentorship, training and networking programs that advance innovative expertise and skillsets enabling the integration of new technologies and methods in the infection and immunity community.
- Increase in the number of targeted research initiatives that enable enhanced participation of underrepresented groups to achieve equitable outcomes in career progression.
- 5 Years
- Growth in the proportion of researchers from underrepresented groups who have successfully transitioned to establish stable careers and are well integrated in infection and immunity research initiatives and events.
- Growth in the number of researchers integrating innovative skillsets, technologies and methods in their research to advance careers in infection and immunity research.
Anticipated Outcome
An increasingly inclusive and diverse infection and immunity research community building the skills needed to make valuable contributions to individual and collaborative research programs, and pursuing fulfilling careers not impeded by race, gender and other intersecting factors.

Strategic Goal: Infection & Immunity Knowledge Mobilization
Foster and Enable Knowledge Mobilization and Implementation of Research Results
Seventeen years! This is the frequently cited average time it takes for a scientific discovery to change clinical practice. To shorten this lag, we need to pair research with active knowledge mobilization so that promising discoveries make their way into Canada’s health systems as policies, practices, programs and products for improved decision making, diagnostics, prevention, intervention, and care solutions.
Traditional knowledge translation frequently focused on the dissemination of knowledge at the end of the research project, with little uptake and use. Today, knowledge mobilization involves the co-creation, translation, synthesis, implementation, and dissemination of new knowledge between researchers and knowledge users. This contemporary concept of knowledge mobilization is the focus of this Strategic Goal. More effective problem definition and rapid implementation of research findings can be facilitated by engaging knowledge users, including people with living and lived experience, healthcare providers, policymakers, industry and the public, early in the research process to inform the research questions, approaches and dissemination strategies. While traditional end-of-grant knowledge mobilization remains a relevant dissemination strategy, III will promote integrated knowledge mobilization because it can strengthen connections between researchers and evidence-based decision making, increase public science literacy, and accelerate our ability to turn knowledge into action.
This Strategic Goal aligns with CIHR’s mandate to excel in the mobilization of new knowledge to improve the health of Canadians and was also identified as a priority in the 2018 III Institute External Review.
Strategic Priorities
- Support training on knowledge mobilization including with decision makers to inform policies and practice.
- Advance people with living and lived experience and community engagement throughout the research process.
- Foster interactions between researchers and industry through public-private partnerships to accelerate product development.
A Path Forward
We will invest in training opportunities in best practices to optimize the co-creation of research questions and foster a dynamic and iterative knowledge mobilization process. To quickly mobilize knowledge, we will create opportunities whereby the infection and immunity research community can connect with all types of knowledge users, and then deepen these relationships through partnerships. To accelerate the commercialization of products originating from research, we will create opportunities for our researchers to interact with non-academic partners and industry stakeholders.
Examples of How We Will Evaluate Success
- 1-3 Years
- Increase in the number of infection and immunity research initiatives providing training in and requiring knowledge mobilization.
- Growth in the number of infection and immunity programs facilitating partnerships between academic and non-academic partners to identify and/or address infection and immunity knowledge, product and policy needs.
- 5 Years
- Growth in the connections and partnerships established between academic and non-academic partners to identify and/or address infection and immunity knowledge, product and policy needs.
- Increase in knowledge mobilization activities within the infection and immunity research community.
Anticipated Outcome
Researchers integrating decision makers, health practitioners, people with living and lived experience, communities and industry in their research to co-create new solutions and accelerate translation and uptake for improved detection, treatment, prevention and care that improves the health of Canadians.
Cross-Cutting Principles
The following cross-cutting principles will be applied to drive the Strategic Goals outlined in previous sections. For III to be successful in achieving its Strategic Goals, an ongoing dialogue with our researchers and partners is essential.Together, we will pursue bold ideas and drive a more inclusive concept ofresearch excellence. This shared responsibility is reflected in our approach to the cross-cutting principles of equity, diversity and inclusion; collaboration and partnership; communications and engagement; and monitoring and learning, where for each principle we outline the roles for the Institute and the research community. These principles will shape not only how we lead and support the infection and immunity research community, but also the new dynamic relationship we look to foster moving forward.
Equity, Diversity & Inclusion (EDI)
The Institute
We will embed the principles of fairness, representation and valued participation—from an intersectionality perspective—in our initiatives, peer-review panels and Advisory Board. We will contribute to CIHR’s Action Plan to address systemic racism in the health research funding system. Given that the Tri-Agency self-identification Equity and Diversity Questionnaire will be implemented in all CIHR funding initiatives, III will ensure to use this information to continuously learn and improve its practice.

Infection & Immunity Research Community
The Institute will continue to enable the research community to develop the skills needed and implement best practices to mitigate unconscious bias, integrate EDI into their research teams and sex- and gender-based analysis plus (SGBA+) into their research and peer review activities.
Together we will foster a research culture that realizes the full benefit of Canada’s diverse talent pool.
Collaborations & Partnerships
The Institute
We will create and strengthen connections and partnerships and maintain consistent communication with strategically aligned national and international players to address the Government of Canada’s priorities, and leverage the funding, expertise and resources needed to deliver excellence in infection and immunity research.

Infection & Immunity Research Community
The Institute will support infection and immunity researchers to establish collaborations across institutions, communities, disciplines, sectors, research pillars and borders to increase capacity and enhance the mobilization of new knowledge and the impact of research results.
Together we will leverage infection and immunity funding and strengthen Canada’s position as a global leader and key research collaborator.
Communications & Engagement
The Institute
We will continue to promote Canadian research on national and international stages and position III and our research community as a reliable source of scientific information. We will continue to raise awareness about III, our Strategic Goals, Priorities, and initiatives. To ensure our work remains relevant within a rapidly evolving research environment, we will proactively connect with and engage the research community.

Infection & Immunity Research Community
As both III and its research community have a growing role in communicating research outputs and their significance to the public, we will help researchers build the skills needed to provide information and promote the benefits of science and research with the media, public and decision makers. We will encourage and provide opportunities for the research community to engage with and provide feedback to III and CIHR.
Together we will continue to grow the infection and immunity research community’s reputation as a reliable source of accurate and timely information and promote the benefits of science and research for our society.
Monitoring & Learning
The Institute
We will identify and monitor performance metrics to assess the outputs, outcomes and impact of III’s investments and partnerships and provide an evidence base to optimize initiatives, strengthen the integration of EDI principles and evaluate our contribution to improving equitable health outcomes and the Sustainable Development Goals.

Infection & Immunity Research Community
The Institute will support an efficient approach for the infection and immunity research community’s reporting on the outputs, outcomes and impact of their research and challenges encountered. This will enable III to monitor the outcomes of strategic investments and allow continuous improvement and application of lessons learned that will benefit the research community as a whole.
Together we will assess Canada’s progress towards new knowledge, policies, practices, programs, and products that will help inform decisions on new initiatives and ultimately strengthen the infection and immunity research environment in Canada.
Performance Monitoring and Learning
A monitoring plan will be developed by the Institute to regularly assess the progress, challenges and impact of strategically funded initiatives and proactively course correct as needed. We are committed to this continued application of lessons learned to ensure targeted outcomes are met, and we can quickly pivot as needed, to respond to emerging research priorities. This new Strategic Plan will enhance the Institute’s impact on infection and immunity research and our program operations by improving the quality, effectiveness, and efficiency of activities.
Over the next year, III will develop both an Implementation Plan, which will include specific activities designed to advance the priorities of each Strategic Goal, and a corresponding Performance Measurement Framework (PMF). The PMF will be based on a data-driven, multidimensional model that incorporates a range of evaluative approaches and tools to monitor the impact of the Strategic Plan and III’s initiatives. This will include both qualitative and quantitative key performance indicators aligned to each Strategic Priority and their corresponding anticipated outcome for reporting. The Implementation Plan and the PMF will be developed with support from the III Institute Advisory Board, input from relevant CIHR branches, and in collaboration with the CIHR Integrated Planning and Results Team.
Impact
As we work together to tackle the 21st century research priorities outlined in this Strategic Plan, we will continue building an infection and immunity research community in Canada that is a) more connected, inclusive, and diverse; b) is trained and has expertise in next generation technologies; and c) can lead and respond to current and emerging infection and immunity health challenges globally and in Canada. This thriving community will drive research impact through strong partnerships with industry, decision makers, communities, and international partners. The priorities of this plan will also contribute to several United Nations Sustainable Development Goals (SDG), including SDG #3 "Ensure healthy lives and promote well-being for all at all ages,"
#5 "Achieve gender equality and empower all women and girls,"
#10 "Reduce inequality within and among countries,"
#9 "Build resilient infrastructure, promote inclusive and sustainable industrialization and foster innovation,"
and #13 "Take urgent action to combat climate change and its impact."
As we look ahead to the future, we are excited to continue working with our world-class infection and immunity research community to build this forward-looking vision. Together, we will work towards our common vision of achieving equitable health outcomes for people in Canada and around the world.
Acknowledgements
Many groups and individuals have contributed to the development of this Strategic Plan. We would first like to acknowledge the members of the III IAB for their advice, direction and support throughout this process.
III Institute Advisory Board
Between May 2019 and November 2020

Brian J. Ward
Chair
Professor,
Medicine & Microbiology,
Research Institute of the McGill University Health Centre

Jean S. Marshall
Vice-Chair
Professor,
Microbiology and Immunology,
Arthur B. McDonald Chair,
Dalhousie University

Marcel Behr
Professor of Medicine,
McGill University

John Conly
Professor of Medicine,
Department of Medicine (Infectious Diseases),
Cumming School of Medicine,
University of Calgary and Alberta Health Services

Sarah Crome
Scientist,
University Health Network,
Toronto General Hospital Research Institute,
Multi Organ Transplant Program
Assistant Professor,
University of Toronto,
Faculty of Medicine,
Department of Immunology

Kimberly Elmslie
Assistant Deputy Minister,
Health Promotion and Chronic Disease Prevention Branch,
Public Health Agency of Canada

Aida Fernandes
Executive Director,
IMAGINE Network

John R. Gordon
Professor,
Department of Medicine,
University of Saskatchewan

Trevor Hart
Ontario HIV Treatment Network (OHTN) Applied Research Chair in Gay and Bisexual Men's Health
Director,
HIV Prevention Lab
Professor,
Department of Psychology,
Ryerson University

Anthony M. Jevnikar
Professor of Medicine, Surgery, Microbiology and Immunology,
University of Western Ontario
Co-Director, Multi Organ Transplant Program,
London Health Sciences Centre,
University Hospital,
London, Ontario

Pauline Johnson
Professor,
Department of Microbiology & Immunology,
University of British Columbia,
Vancouver

Manisha Kulkarni
Associate Professor,
School of Epidemiology and Public Health,
University of Ottawa
Director,
Interdisciplinary Spatial Informatics for Global Health (INSIGHT) Lab,
University of Ottawa

Barbara Papadopoulou
Full Professor,
Department of Microbiology-Infectious Disease and Immunology,
CHU de Quebec Research Center,
Université Laval

Christopher Power
Professor of Neurology,
University of Alberta
Canada Research Chair in Neurologic Infection and Immunity
Participants of the Engagement Process
We also acknowledge the members of our community, including researchers, trainees, clinicians, partners, policy makers, people with living and lived experience and other members of the public, who’s valuable input significantly shaped the strategic goals and priorities within the Strategic Plan. In particular, we would like to thank all participants of the Engagement Workshop and Focus Groups (listed below), who dedicated significant time and effort to the engagement process. We are especially grateful to IIPH and the Indigenous communities, scholars and organizations for their valuable contributions.
- Hamilton Engagement Workshop, January 8, 2020
- Toronto Engagement Workshop, January 30, 2020
- Calgary Engagement Workshop, February 11, 2020
- Quebec City Engagement Workshop, March 12, 2020
- Atlantic Provinces Engagement Workshop, September 17, 2020
- Greater Vancouver and Victoria Area Engagement Workshop, September 21, 2020
- Greater Montreal Area Engagement Workshop, September 22, 2020
- Prairie Provinces Engagement Workshop, September 29, 2020
- Sex and Gender Focus Group, October 19, 2020
- Early Career Investigators Focus Group, October 20, 2020
- Racial Equity, Diversity and Inclusion Focus Group, October 26, 2020
- Knowledge Mobilization Focus Group, October 27, 2020
- National and International Partnerships Focus Group (2 sessions), November 2-5, 2020
- Indigenous Health Focus Group (3 sessions), November 24-26, 2020
III Staff

Puja Bagri
Project Analyst

Geneviève Boily-Larouche
Assistant Scientific Director

Édith Brochu
Project Manager – Strategic Research Initiatives

Deborah Khursigara
Project Manager – Strategic Research Initiatives

Katherine Labenski
Specialist, Events and Communications

Tiffany Pattison-MacLeod
Administrative and Finance Manager

Élisabeth Pagé
Assistant Scientific Director
Until May 2020

Sharon Ralph
Financial Coordinator

Jaime Tabatznik
Research Assistant
Until May 2021

Danielle Vitali
Strategic Operations Manager
Special Thanks
- CIHR Institute of Gender and Health
- Marc Ouellette, Université Laval
- McMaster University
- Shift Health
- Office/Bureau
- EarthLore
- Date modified: